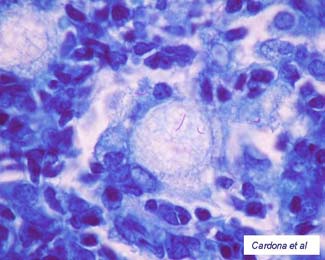
Potser el lapse de temps entre un TST i un TIGRA influeix en el resultat d'aquest últim

- Home




Noroviruses hyperesistance
Acute gastroenteritis (AGE), often related to noroviruses, is one of the most common diseases suffered by the population. Noroviruses affect the stomach and intestines and are easily transmissible through human contact or in enclosed spaces, which would explain why they appear relatively frequently during...

Antiplatelet Therapy is the key for the treatment of coronary atherothrombosis
The future of ischaemic heart disease treatment and its most dangerous pathology, atherothrombosis, will depend on the improvement in scientific research. Since a definitive treatment for this disease has not yet...


FNR Protein: a step forward in antimicrobial research
At the laboratory of Bacterial Molecular Genetics, from the Institute of Biotechnology and Biomedicine of the UAB, researchers have studied which existing mechanisms of genetic regulation allow some bacteria to retain the ability to develop under...


